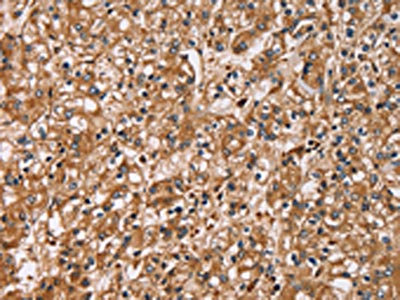

HTR3C Antibody
-
中文名稱:HTR3C兔多克隆抗體
-
貨號(hào):CSB-PA869025
-
規(guī)格:¥1100
-
圖片:
-
The image on the left is immunohistochemistry of paraffin-embedded Human prostate cancer tissue using CSB-PA869025(HTR3C Antibody) at dilution 1/30, on the right is treated with fusion protein. (Original magnification: ×200)
-
The image on the left is immunohistochemistry of paraffin-embedded Human brain tissue using CSB-PA869025(HTR3C Antibody) at dilution 1/30, on the right is treated with fusion protein. (Original magnification: ×200)
-
Gel: 8%SDS-PAGE, Lysate: 40 μg, Lane: HT29 cells, Primary antibody: CSB-PA869025(HTR3C Antibody) at dilution 1/500, Secondary antibody: Goat anti rabbit IgG at 1/8000 dilution, Exposure time: 20 seconds
-
-
其他:
產(chǎn)品詳情
-
Uniprot No.:
-
基因名:HTR3C
-
別名:HTR3C; 5-hydroxytryptamine receptor 3C; 5-HT3-C; 5-HT3C; Serotonin receptor 3C
-
宿主:Rabbit
-
反應(yīng)種屬:Human
-
免疫原:Fusion protein of Human HTR3C
-
免疫原種屬:Homo sapiens (Human)
-
標(biāo)記方式:Non-conjugated
-
抗體亞型:IgG
-
純化方式:Antigen affinity purification
-
濃度:It differs from different batches. Please contact us to confirm it.
-
保存緩沖液:-20°C, pH7.4 PBS, 0.05% NaN3, 40% Glycerol
-
產(chǎn)品提供形式:Liquid
-
應(yīng)用范圍:ELISA,WB,IHC
-
推薦稀釋比:
Application Recommended Dilution ELISA 1:1000-1:2000 WB 1:200-1:1000 IHC 1:50-1:200 -
Protocols:
-
儲(chǔ)存條件:Upon receipt, store at -20°C or -80°C. Avoid repeated freeze.
-
貨期:Basically, we can dispatch the products out in 1-3 working days after receiving your orders. Delivery time maybe differs from different purchasing way or location, please kindly consult your local distributors for specific delivery time.
-
用途:For Research Use Only. Not for use in diagnostic or therapeutic procedures.
相關(guān)產(chǎn)品
靶點(diǎn)詳情
-
功能:This is one of the several different receptors for 5-hydroxytryptamine (serotonin), a biogenic hormone that functions as a neurotransmitter, a hormone, and a mitogen. This receptor is a ligand-gated ion channel, which when activated causes fast, depolarizing responses. It is a cation-specific, but otherwise relatively nonselective, ion channel.
-
基因功能參考文獻(xiàn):
- Our study indicates, for the first time, an association between variants of HTR3C and severity of chemotherapy-induced symptoms PMID: 24477975
- The association findings of the HTR3C and the HTR3E remained significant after correction for the number of variants investigated. PMID: 23928294
- Data show that 5-HT3C, 5-HT3D, and 5-HT3E subunits are coexpressed with 5-HT3A in cell bodies of myenteric neurons, and that 5-HT3A and 5-HT3D were expressed in submucosal plexus of the human large intestine. PMID: 21192076
- Six functional and coding variants of the subunit genes HTR3A, HTR3B as well as the novel HTR3C, HTR3D, and HTR3E subunits in the response to haloperidol or risperidone, were assessed. PMID: 19794330
- Polymorphisms in the subunit gene HTR3C of the serotonin receptor may be involved in the pathogenesis of pregnancy-associated nausea. PMID: 20021265
- Polymorphisms in the HTR3C gene could serve as a predictive factor for chemotherapy-induced nausea and vomiting in patients undergoing moderately emetogenic chemotherapy. PMID: 18389280
- HTR3C represents a novel candidate locus for autism spectrum disorders and should be tested in other populations. PMID: 19035560
顯示更多
收起更多
-
亞細(xì)胞定位:Cell membrane; Multi-pass membrane protein. Note=Presumably retained within the endoplasmic reticulum unless complexed with HTR3A.
-
蛋白家族:Ligand-gated ion channel (TC 1.A.9) family, 5-hydroxytryptamine receptor (TC 1.A.9.2) subfamily, HTR3C sub-subfamily
-
組織特異性:Expressed in many tissues including adult brain, colon, intestine, lung, muscle and stomach as well as fetal colon and kidney.
-
數(shù)據(jù)庫鏈接:
Most popular with customers
-
-
YWHAB Recombinant Monoclonal Antibody
Applications: ELISA, WB, IHC, IF, FC
Species Reactivity: Human, Mouse, Rat
-
Phospho-YAP1 (S127) Recombinant Monoclonal Antibody
Applications: ELISA, WB, IHC
Species Reactivity: Human
-
-
-
-
-